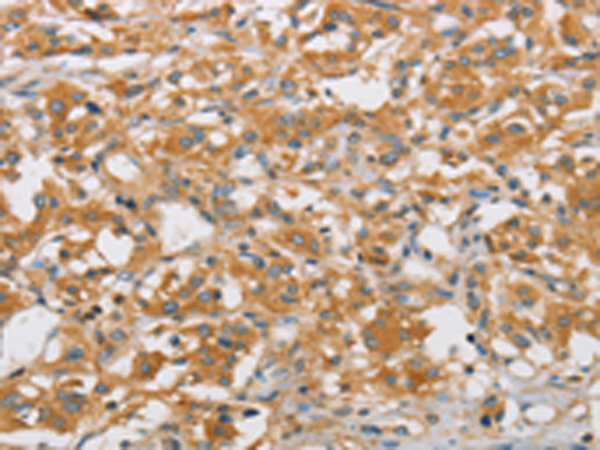

-
分类: 科研抗体货号: P07889别名: GEF3; STA3; XPLN应用: IHC反应种属: Human, Mouse
-
分类: 科研抗体货号: P07855别名: AP17; HHC3; CLAPS2; AP17-DELTA应用: IHC反应种属: Human, Mouse, Rat
-
分类: 科研抗体货号: P07888别名: PEM2; EIEE8; PEM-2; HPEM-2; COLLYBISTIN应用: WB,IHC反应种属: Human, Mouse, Rat
-
分类: 科研抗体货号: P07874别名: KAP; Kdap; NAP1; NAPA; SNAPA应用: WB,IHC反应种属: Human, Mouse
-
分类: 科研抗体货号: P07887别名: P50; P85; PAK3; PIXB; COOL1; P50BP; COOL-1; P85SPR; BETA-PIX; P85COOL1; Nbla10314应用: WB,IHC反应种属: Human, Mouse, Rat
-
分类: 科研抗体货号: P07873别名: AOA; AOA1; AXA1; EAOH; EOAHA; FHA-HIT应用: IHC反应种属: Human, Mouse, Rat
-
分类: 科研抗体货号: P07886别名: LSC; GEF1; LBCL2; SUB1.5; P115-RHOGEF应用: IHC反应种属: Human, Mouse, Rat
-
分类: 科研抗体货号: P07904别名: GDE2; PP1665应用: WB反应种属: Human, Mouse
-
分类: 科研抗体货号: P07883别名: KAIA0053应用: WB,IHC反应种属: Human
-
分类: 科研抗体货号: P07903别名: TIP; ESA1; PLIP; TIP60; cPLA2; HTATIP; ZC2HC5; HTATIP1应用: IHC反应种属: Human, Mouse, Rat

鄂公网安备42018502007531号
鄂公网安备42018502007531号

